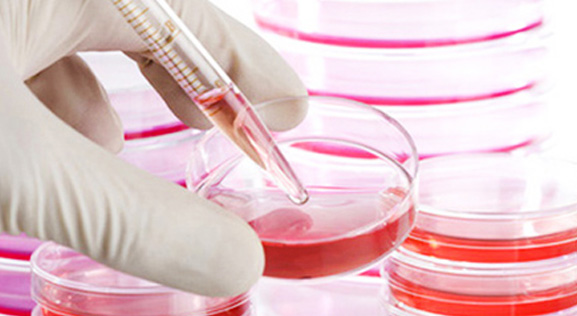
33

公司新闻
提供优质和专业的售前技术咨询、方案设计和售后服务
藻类的研究在我国社会主义经济发展中起着重要的作用,可广泛应用于工业、农业、医药、环境处理等领域,藻类研究成为众多科研机构的重点研究课题。
为了顺应在课程设计上体现重综合,重衔接,重生活,重方法,重探索的科学实践理念,真正落实科学实践活动,提升学生核心素养。Countstar自动细胞计数仪受到了北京广渠门中学校方的认可与引进,成功解决了校方就如何让中学生生动、清晰地了解细胞培养的常规实...
经过白泽医疗器械科研人员的层层验证(传统血球计数板计数确认、行业同类产品比较),Countstar®自动细胞计数仪凭借准确、稳定的结果,便携的操作性能及强大的数据管理系统,完全消除了科研人员的忧虑,获得了客户的信赖与认可。Countstar®顺利入驻抗体组...
11月初冬Countstar来到了山东大学和哈尔滨医科大学,十一月的北方校园早已寒风瑟瑟,实验室里显得有些冷清,而Countstar的到来点燃了师生们的热情。
适用于浓度范围为1×10E4~3×10E7,直5~180μm的哺乳动物细胞、昆虫细胞、肿瘤细胞及部分浮游生物的浓度。
您是否还在被用血球计数板统计细胞浓度而折磨,您是否还在纠结两次计数结果之间偏差20%,到底要相信那一次准确呢。那您有考虑过为什么两次计数之间会存在如此大的误差呢?
10月16-19日Countstar亮相第三届中美流式细胞技术研讨会。作为细胞分析技术的研讨盛会,此次研讨会汇集了各个国家的众多知名细胞研究专家学者,大家就当前的流式技术发展现状以及应用实践等方面进行了探讨。